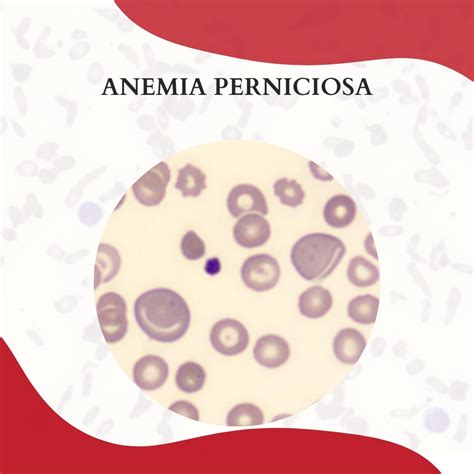

La anemia es una afección que consiste en la falta de glóbulos rojos sanos. La anemia perniciosa es una disminución en los glóbulos rojos que ocurre cuando los intestinos no pueden absorber apropiadamente la vitamina B12. Es un tipo de anemia por deficiencia de vitamina B12, esencial para la producción de glóbulos rojos.
Esta vitamina se obtiene del consumo de alimentos como carne de res, carne de aves, mariscos, huevos y productos lácteos. Una proteína especial, llamada factor intrínseco (FI), ayuda a que la vitamina B12 pueda ser absorbida por los intestinos. Esta proteína es secretada por células en el estómago. Cuando el estómago no produce suficiente factor intrínseco, el intestino no puede absorber apropiadamente la vitamina B12.
Por otro lado, el vitíligo es una enfermedad de la piel que se caracteriza por la pérdida de pigmento en las células de la piel, llamadas melanocitos. Esto resulta en la aparición de manchas blancas simétricas en diferentes áreas del cuerpo. El vitíligo no causa dolor ni molestias físicas, pero puede tener un impacto negativo en la autoestima y la calidad de vida de las personas que lo padecen.

Causas de la Anemia Perniciosa
Las causas más comunes de anemia perniciosa abarcan:
- Debilitamiento del revestimiento del estómago (gastritis atrófica).
- Una afección autoinmunitaria: El sistema inmunitario del cuerpo ataca a la proteína del factor intrínseco actual o a las células en el revestimiento del estómago que lo producen.
- Anemia perniciosa congénita: En pocas ocasiones, la anemia perniciosa se transmite de padres a hijos. Los bebés con este tipo de anemia no producen suficiente factor intrínseco o no pueden absorber apropiadamente la vitamina B12 en el intestino delgado.
La causa principal de la anemia perniciosa es tener una enfermedad autoinmune como la enfermedad de Addison, enfermedad de Crohn, la enfermedad de Graves, miastenia gravis, diabetes tipo 1, vitíligo, síndrome de Sjögren o celiaquía por la que el sistema inmunitario ataca a la proteína del factor intrínseco. Otra causa muy frecuente es el debilitamiento del revestimiento del estómago (gastritis atrófica).
Factores de Riesgo de la Anemia Perniciosa
En los adultos, los síntomas de la anemia perniciosa por lo general no se ven hasta después de la edad de 30 años. La edad promedio de diagnóstico es a los 60 años.
Usted es más propenso a presentar esta enfermedad si:
- Es escandinavo o europeo nórdico.
- Tiene antecedentes familiares de la afección.
Ciertas enfermedades también pueden elevar el riesgo, entre ellas:
- Enfermedad de Addison
- Enfermedad de Graves
- Hipoparatiroidismo
- Hipotiroidismo
- Miastenia grave
- Pérdida de las funciones normales de los ovarios antes de los 40 años de edad (disfunción ovárica primaria)
- Diabetes tipo 1
- Disfunción testicular
- Vitiligo
- Síndrome de Sjögren
- Enfermedad de Hashimoto
- Celiaquía
La anemia perniciosa también se puede presentar después de una cirugía de derivación gástrica.
Síntomas de la Anemia Perniciosa
Es posible que algunas personas no tengan síntomas. Los síntomas pueden ser leves. Pueden incluir:
- Diarrea o estreñimiento
- Náusea
- Vómitos
- Fatiga, falta de energía o mareo al pararse o hacer esfuerzo
- Pérdida del apetito
- Piel pálida (ictericia leve)
- Dificultad para respirar, sobre todo durante el ejercicio
- Acidez
- Inflamación y enrojecimiento de la lengua o encías que sangran
Si tiene niveles bajos vitamina B12 por un largo tiempo, puede presentar daño al sistema nervioso. Los síntomas pueden abarcar:
- Confusión
- Lapsos breves de pérdida de memoria
- Depresión
- Pérdida del equilibrio
- Entumecimiento y hormigueo en las manos y los pies
- Problemas de concentración
- Irritabilidad
- Alucinaciones
- Delirio
- Atrofia del nervio óptico
Anemia Perniciosa - Mucho cuidado - Doctor Rojas.
Tratamiento de la Anemia Perniciosa
El objetivo del tratamiento es incrementar los niveles de vitamina B12:
- El tratamiento consiste en una inyección de vitamina B12 una vez al mes.
- Las personas con niveles muy bajos de vitamina B12 pueden necesitar más inyecciones al principio.
- Algunas personas pueden ser tratadas adecuadamente tomando grandes dosis de suplementos de vitamina B12 por vía oral.
- También se puede administrar un cierto tipo de vitamina B12 a través de la nariz.
Para tratar la anemia perniciosa, hay básicamente una necesidad que es la de aumentar la presencia de vitamina B12 en el cuerpo. Para ello, el médico recetará suplementos vitamínicos mediante inyección o ingestión oral de forma periódica, normalmente, una vez al mes. También hay que mejorar la dieta para conseguir que los alimentos que comemos tengan los niveles adecuados de la vitamina que carece el organismo.
La prevención de este trastorno pasa especialmente por seguir una dieta equilibrada y rica en vitamina B12. También hay que mejorar la dieta para conseguir que los alimentos que comemos tengan los niveles adecuados de la vitamina que carece el organismo. La vitamina B12 se encuentra en alimentos como la carne, pollo, mariscos, huevos y leche.
Causas del Vitíligo
El vitiligo es una condición en la que los melanocitos, que son responsables de producir el pigmento de la piel, dejan de funcionar correctamente o mueren. Esto resulta en la pérdida de color y la aparición de manchas blancas en la piel.
Las causas exactas del vitíligo no se conocen por completo, pero se cree que puede ser el resultado de un trastorno autoinmune en el cual el sistema inmunológico ataca y destruye los melanocitos. Puede estar asociado a otras enfermedades autoinmunes, como la diabetes tipo 1, la tiroiditis de Hashimoto, la enfermedad celíaca, la artritis reumatoide o la psoriasis.
Además, se han identificado varias teorías científicas y médicas que buscan explicar su origen:
- Teoría genética: Existe una fuerte asociación familiar en el desarrollo del vitíligo.
- Teoría autoinmune: En esta enfermedad, el sistema inmunológico ataca los melanocitos, células encargadas de producir el pigmento en la piel.
- Teoría neurogénica: Se ha observado un aumento en la síntesis de neuropéptidos como la epinefrina, que puede dañar los melanocitos.
- Teoría bioquímica: Anormalidades bioquímicas en los pacientes pueden generar radicales libres que causan la muerte de los melanocitos.
- Teoría melanocitorrágica: El trauma repetitivo sobre la piel puede causar el desprendimiento de melanocitos, afectando la pigmentación.
Tipos de Vitíligo
El vitíligo tiene 3 tipos según las manchas blancas en la piel:
- No segmentario: Afecta a ambos lados del cuerpo y tiene varias formas.
- Segmentario: Afecta a un lado o una parte y es menos común.
- Vitíligo acrofacial: Afecta partes distales y a la región facial.
Síntomas del Vitíligo
El primer signo del vitíligo suele ser la aparición de una mancha blanca en alguna parte del cuerpo, que puede ser pequeña o grande, redonda u ovalada, bien delimitada o difusa. La mancha puede permanecer estable o crecer con el tiempo, así como aparecer otras manchas en otras zonas del cuerpo.
La evolución del vitíligo y la respuesta al tratamiento es muy variable según cada paciente: el vitíligo puede repigmentar de forma espontánea o con tratamiento, puede mantenerse estable o puede extenderse a pesar de realizar los tratamientos disponibles.
Los síntomas de la enfermedad tienen una distribución característica. Frecuentemente en la cara, axilas, la ingle, en las areolas, en la parte genital o también puede manifestarse de forma asimétrica a nivel de las extremidades como son en los nudillos de las manos, en los codos o en las rodillas.
Diagnóstico del Vitíligo
El diagnóstico se basa en la exploración clínica de la piel y en la historia médica del paciente. El médico puede observar las manchas blancas con una lámpara de Wood, que emite una luz ultravioleta que hace que las áreas despigmentadas se vean más claras. También puede solicitar análisis de sangre para descartar otras enfermedades asociadas al vitíligo, como las alteraciones tiroideas o la anemia perniciosa. En algunos casos, puede ser necesario realizar una biopsia de piel para confirmar el diagnóstico.
Tratamiento del Vitíligo
El tratamiento del vitíligo tiene como objetivo detener o reducir la progresión de las manchas blancas y restaurar el color de la piel. Sin embargo, no existe una cura definitiva para esta enfermedad y los resultados pueden variar según cada caso.
El tratamiento tópico debe ser formulado por un dermatólogo, especialmente en pacientes con pocas lesiones. Las opciones incluyen:
- Medicamentos tópicos: Cremas o geles que se aplican sobre la piel y contienen sustancias que estimulan la producción de melanina o modulan la respuesta inmunitaria.
- Corticoides tópicos, sistémicos o intralesionales: Usados en lesiones pequeñas y localizadas.
- Inmunomoduladores y antioxidantes: Tratamientos recientes con buena respuesta clínica.
- Análogos de la vitamina E y la melanotropina: Terapias para estimular la pigmentación.
- Vitamina D tópica: Puede desempeñar un papel coadyuvante en la repigmentación de las lesiones vitiliginosas.
- Fototerapia: Consiste en exponer la piel a una luz artificial que activa los melanocitos y favorece la repigmentación.
- Micropigmentación: Consiste en inyectar pigmentos artificiales en la piel para imitar el color natural. Es una técnica similar al tatuaje, pero menos profunda y más precisa.
- Despigmentación: Consiste en eliminar el color de la piel sana para igualarlo al de la piel afectada por el vitíligo. Se realiza mediante la aplicación de cremas que contienen sustancias que inhiben la melanina, como el monobenciléter de hidroquinona. En casos avanzados, donde más del 50% de la piel está despigmentada, puede considerarse la despigmentación completa para mejorar la calidad de vida del paciente.

El enfoque del tratamiento depende de la edad, la localización de las lesiones, el porcentaje de superficie corporal afectada y la progresión de la enfermedad.
Relación entre Anemia Perniciosa y Vitíligo
Es importante señalar que el vitíligo puede estar asociado a otras enfermedades autoinmunes, como la diabetes tipo 1, la tiroiditis de Hashimoto, la enfermedad celíaca, la artritis reumatoide o la psoriasis. Además, se ha visto que pacientes que sufren de enfermedades de la tiroides, diabetes o inclusive pacientes con anemia perniciosa pueden presentar este tipo de enfermedad.
Se han documentado como factores de riesgo el género femenino y antecedente de autoinmunidad familiar. Este caso ejemplifica el término de poliautoinmunidad, con base en la definición previamente descrita y en los patrones fenotípicos que este tipo de pacientes muestra.
Con estas nuevas definiciones se trata de eliminar el término de "enfermedades secundarias autoinmunitarias" porque se ha demostrado que lo más probable es que los pacientes que padecen dos o más de estas afecciones compartan la misma etiopatogenia. Poliautoinmunidad es un término propuesto para englobarlas y actualmente se sabe que un paciente con una enfermedad autoinmunitaria está predispuesto a padecer alguna otra de esta causa, que puede ser sistémica u órgano específica.

Tabla 1: Comparación entre Anemia Perniciosa y Vitíligo
| Característica | Anemia Perniciosa | Vitíligo |
|---|---|---|
| Definición | Disminución de glóbulos rojos por falta de absorción de vitamina B12. | Pérdida de pigmento en la piel debido a la disfunción de los melanocitos. |
| Causa Principal | Falta de factor intrínseco (a menudo por autoinmunidad). | Desconocida, pero se cree que es autoinmune, genética y ambiental. |
| Síntomas | Fatiga, debilidad, problemas neurológicos, lengua inflamada. | Manchas blancas en la piel, cabello y mucosas. |
| Tratamiento | Inyecciones o suplementos de vitamina B12. | Cremas, fototerapia, despigmentación, micropigmentación. |
tags: #anemia #perniciosa #y #vitiligo